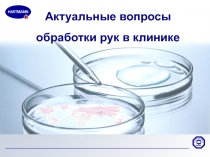
Актуальные вопросы обработки рук в клинике

Разделы презентаций
- Разное
- Английский язык
- Астрономия
- Алгебра
- Биология
- География
- Геометрия
- Детские презентации
- Информатика
- История
- Литература
- Математика
- Медицина
- Менеджмент
- Музыка
- МХК
- Немецкий язык
- ОБЖ
- Обществознание
- Окружающий мир
- Педагогика
- Русский язык
- Технология
- Физика
- Философия
- Химия
- Шаблоны, картинки для презентаций
- Экология
- Экономика
- Юриспруденция
Презентации, проекты, доклады на разные темы в PowerPoint
- 10811
- 10812
- 10813
- 10814
- 10815
- 10816
- 10817
- 10818
- 10819
- 10820
- 10821
- 10822
- 10823
- 10824
- 10825
- 10826
- 10827
- 10828
- 10829
- 10830
Уважаемые посетители, добро пожаловать на сайт готовых презентаций!
TheSlide.ru - это сайт для удобного хранения презентаций, а также площадка для обмена опытом и знаниями. На нашем портале, Вы найдете готовые презентации, доклады, проекты, посвященные самым разным темам. Эти учебные материалы будут очень полезны для учителей и учеников на уроках в классе. Любой посетитель может найти подходящую по содержимому презентацию на любую тему для 1,2,3,4,5,6,7,8,9,10,11 класса по английскому языку, астрономии, алгебре, окружающему миру, биологии, географии, геометрии, информатике, истории, литературе, математике, медицине, музыке, МХК, ОБЖ, обществознанию, русскому языку, технологии, физике, философии, химии, экономике и скачать на свой компьютер, а также поделиться с друзьями в социальных сетях. Все презентации созданы в формате PowerPoint, поэтому если необходимо, можно дополнить их новыми слайдами, видео или музыкой. На сайте постоянно появляются новые востребованные материалы, поэтому остается только найти и скачать презентацию на заданную тему.
Успехов в учебе!
С уважением,
Администрация сайта TheSlide.ru